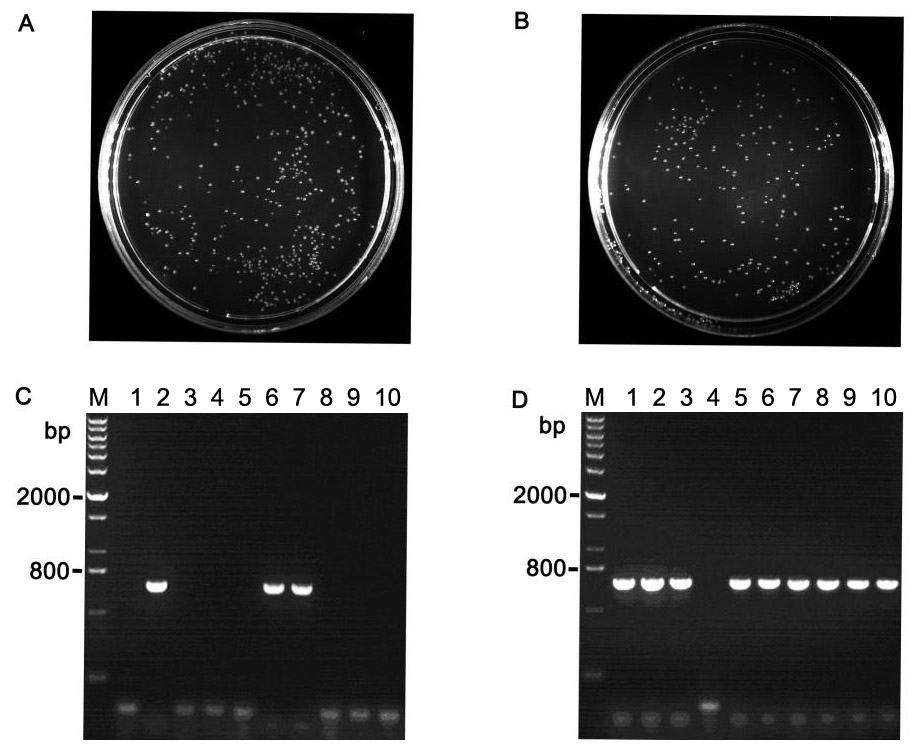
产品细节图片3

相关产品推荐更多 >
万千商家帮你免费找货
0 人在求购买到急需产品
- 详细信息
- 文献和实验
- 技术资料
- 规格:
1000U
碧云天生产的Antarctic Phosphatase (Thermosensitive),是一种源自南极微生物的、热敏感的重组表达纯化的磷酸酶,可以催化去除DNA、RNA、dNTP、rNTP 5'或3’末端磷酸基团。DNA或RNA 5’端脱去磷酸基团(简称脱磷或去磷)后就不能被连接酶(ligase)所连接,常用于避免载体的自连、提高基因克隆时的阳性率、选择性连接特定序列等。
Antarctic Phosphatase也可以脱去蛋白质丝氨酸、苏氨酸或酪氨酸残基上的磷酸基团。
Antarctic Phosphatase是一种新型碱性磷酸酯酶,在碧云天的各种内切酶和PCR缓冲液中可保持不低于100%的活性,对于各种类型的DNA 5’末端的去磷酸化均可在37℃孵育15分钟即可完成,并且75℃孵育5分钟即可完全失活。
碱性磷酸酶(Alkaline Phosphatase, AP/ALP/AKP/ALKP/ALPase/Alk Phos, EC 3.1.3.1)常被称作碱性磷酸酯酶,是一类水解酶,通过水解磷酸单酯将底物分子上的磷酸基团除去,并生成磷酸根离子和自由的羟基。其去磷酸化作用的底物包括核苷酸、蛋白质和生物碱等,并在碱性条件下最为有效。该酶是一组同功酶的统称。常见的小牛肠碱性磷酸酶(Calf Intestinal Alkaline Phosphatase, CIAP/CIP)被广泛用于二抗等的标记,最终用于蛋白和核酸等的检测,也常用于DNA或RNA 5'和3'末端的去磷酸化(去单磷酸化),特别是质粒的5'末端去磷酸化以避免质粒自连等。
经限制性内切酶酶切的质粒5'端带有磷酸基团,在进行基因克隆时为避免质粒自连,可以使用Antarctic Phosphatase去除5'末端磷酸基团。脱去5'末端磷酸基团的质粒不能发生自连。
本产品主要特点:快速去磷酸化,只需37℃孵育15分钟即可;快速失活,75℃孵育5分钟即可完全失活;使用方便,在各种内切酶和PCR缓冲液中保持不低于100%的活性,可以和质粒DNA的酶切等同时进行;兼容性强,对于5'或3'突出末端、平端等各种DNA的脱磷酸化采用完全相同的操作步骤;适用于后续的连接反应,经Antarctic Phosphatase脱磷酸基团,并75℃孵育5分钟失活后,通过柱纯化或凝胶电泳后切胶回收纯化等适当处理后,可用于后续的连接反应。
用途:通过去除载体或DNA片段5'末端的磷酸基团,防止载体或DNA片段自连;质粒DNA同时进行内切酶消化和脱磷;通过5'末端脱磷,制备用于T4PNK进行5'末端标记的DNA或RNA;去除DNA、RNA、rNTP和dNTP的5'末端的磷酸基团;PCR产物中去除dNTP和焦磷酸根;用于蛋白质丝氨酸、苏氨酸、酪氨酸残基的去磷酸化。
来源:大肠杆菌重组表达。Antarctic Phosphatase通常会形成同源二聚体,其单体的分子量为35kD。
酶活性定义: 1µg线性化的pUC19在37℃孵育30分钟可以导致后续的自连反应抑制率达到95%以上定义为一个活力单位。
纯度:不含DNA外切酶和内切酶,不含RNA酶。
酶储存溶液:10mM Tris-HCl (pH7.4),1mM MgCl2,0.1mM ZnCl2,50% (v/v) glycerol。
Antarctic Phosphatase Reaction Buffer (10X):500mM Bis-Tris-Propane HCl,10mM MgCl2,1mM ZnCl2,pH 6.0。
失活或抑制:75℃加热5分钟可使Antarctic Phosphatase充分失活。EDTA等金属离子螯合剂对Antarctic Phosphatase有抑制作用。
碧云天生产的Antarctic Phosphatase75℃灭活前后的酶活对比(参见图1)。

图1. 碧云天热敏碱性磷酸酶Antarctic Phosphatase 75℃灭活前后的酶活对比。以pNPP为底物进行比色法测定,灭活采用75℃加热处理5分钟。反应体系为:50µl底物缓冲液(10mM pNPP等),2µl稀释125倍后的碧云天Antarctic Phosphatase (圆形和三角形图标分别代表是否经过75℃加热处理5分钟的酶)。混匀后室温反应20分钟,每隔1 min测定一次OD405。
碧云天生产的Antarctic Phosphatase对单酶切后的载体进行脱磷处理可以大大降低载体单酶切后的自连率(参见图2)。

图2. 碧云天生产的Antarctic Phosphatase对BamHI单酶切后的pUC18载体进行脱磷处理可以大大降低载体自连。A. pUC18质粒经BamHI单酶切过夜,不使用碧云天生产的Antarctic Phosphatase进行脱磷处理,然后载体用T4 DNA连接酶进行连接、转化DH5α的实验结果。B. pUC18质粒经BamHI单酶切,使用碧云天生产的Antarctic Phosphatase在37℃脱磷处理15分钟,75℃灭活处理5分钟,然后载体用T4 DNA连接酶进行连接、转化DH5α的实验结果。本产品处理后可以使大于95%的单酶切质粒脱磷而避免自连。
碧云天生产的Antarctic Phosphatase对双酶切后的载体进行脱磷处理可以大大提高克隆的阳性率(参见图3)。
图3. 碧云天生产的Antarctic Phosphatase对EcoRI/BamHI双酶切后的pUC18载体进行脱磷处理可以大大提高克隆的阳性率。A、C. 经EcoRI/BamHI双酶切过夜的pUC18质粒未做脱磷处理,加入EcoRI/BamHI双酶切后600bp的PCR产物片段,然后用T4 DNA连接酶进行连接、转化DH5α的实验结果(A)及从该平板挑取10个单克隆、使用pUC18通用引物、进行菌落PCR的实验结果(C);B、D. 经EcoRI/BamHI双酶切的pUC18质粒使用碧云天生产的Antarctic Phosphatase在37℃脱磷处理15分钟,75℃灭活处理5分钟,柱纯化后加入经EcoRI/BamHI双酶切的后600bpPCR产物片段,然后用T4 DNA连接酶进行连接、转化DH5α的实验结果(B)及从该从平板挑取10个单克隆、使用pUC18通用引物、进行菌落PCR的实验结果(D)。
包装清单:| 产品编号 | 产品名称 | 包装 |
| D7028S-1 | Antarctic Phosphatase (5U/µl) | 200µl |
| D7028S-2 | Antarctic Phosphatase Reaction Buffer (10X) | 500µl |
| — | 说明书 | 1份 |
| 产品编号 | 产品名称 | 包装 |
| D7028M-1 | Antarctic Phosphatase (5U/µl) | 1ml |
| D7028M-2 | Antarctic Phosphatase Reaction Buffer (10X) | 2ml |
| — | 说明书 | 1份 |
-20℃保存。
风险提示:丁香通仅作为第三方平台,为商家信息发布提供平台空间。用户咨询产品时请注意保护个人信息及财产安全,合理判断,谨慎选购商品,商家和用户对交易行为负责。对于医疗器械类产品,请先查证核实企业经营资质和医疗器械产品注册证情况。
 文献和实验
文献和实验【共享】Highly Efficient Ligation for Large Inserts
enzyme in a 50 rxn, and the reactions were only complete after 3 hr/each! 2.) Dephosphorylate vector at 37C with Antarctic Phosphatase, using 1ul enzyme/ug DNA. Go 20′ for 5′ overhangs or blunt ends, 1 hr. for 3′ or blunt overhangs. 3.) Titrate
【资源】全面归类网址:毕赤酵母表达各种来源蛋白(细菌,真菌,植物,人类等)
or Kluyveromyces lactis killer toxin signal, functional454Escherichia coli acid phosphatase/phytase (appA2)S, 28.9 U/mg[61]Escherichia coli β-GalactosidaseI, 2.0 ´ 103 U/mg[62]Escherichia coli β-D-glucuronidaseI309Escherichia coli β-LactamaseI[63]Leishmania
 技术资料
技术资料暂无技术资料 索取技术资料











